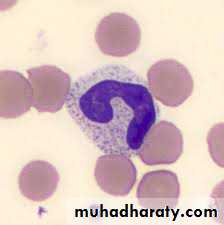

Evaluation of Fever in Infants and Young Children
Dr. Anmar AL-DewachiAssistant Professor of Family Medicine
M.B.Ch.B-MPH-JHSFM
Background
Febrile illness in children younger than 36 months is common and may has potentially serious consequences.As many as 20% of childhood fevers have no apparent cause (fever without source “FWS”) which represents and diagnostic dilemma. A small but significant number of these patients may have a serious bacterial infection (SBI); the risk is greatest among febrile infants and children younger than 36 months.
Serious infections that are not recognized promptly and treated appropriately can cause significant morbidity or mortality.
Definitions
A clinically significant Fever in children younger than 36 months is defined as rectal temperature of (38°C) and more.Fever without source (FWS) is defined as fever for less than 7 days in a child whose medical history and careful physical examination do not reveal the cause of the fever.
• Serious bacterial infections (SBI) include all types of infections that result in risk of morbidity and mortality when diagnosis is delayed.
• Infections that are considered to be SBIs: occult bacteremia (OB), pneumonia, urinary tract infection (UTI), bacterial meningitis, septic arthritis, osteomyelitis, and cellulite.
Pathophysiology
Sepsis ,meningitis, pneumonia, urinary tract infection (UTI), and bacteremia are serious etiologies of fever in infants and young children.Immature immune systems of neonate place them at greater risk of systemic infection, so hematogenous spread of infection is most common in this age group or in patients who are immunocompromised or unimmunized. For these same reasons, infants who have a focal bacterial infection have a greater risk of developing metastatic infection or bacteremia.
The most common bacterial etiologies of serious bacterial infection in this age group:
Streptococcus pneumoniae
Streptococcus agalactiae
Pathophysiology
Neisseria meningitidis
Haemophilus influenzae type b
Listeria monocytogenes
Escherichia coli
Dramatic reduction in the incidence of Streptococcus pneumoniae and Haemophilus influenzae type b (Hib) infections following the widespread use of immunizations against these organisms
Viral infections are common in the young children , however, exclude serious bacterial infection prior to assuming a viral etiology for the fever.
How to measure body temperature in infants and children?
Rectal temperature is the most accurate method in measuring body temperature in infants and children (standard method) and the most inconvenient way.Oral temperature can be used from age of 5 years.
Other methods axillary and tympanic temperature.
Oral and tympanic temperature 0.5-0.6 Ċ < rectal temperature
Axillary temperature 1 Ċ < rectal temperature
Evaluation
The initial evaluation of these patients is directed toward identifying or ruling out serious bacterial infections (SBI).The following questions are important to consider:
• What laboratory investigations are indicated for various age ranges?
• Which patients need in-depth evaluation and treatment?
• Which patients need treatment with antibiotics?
• Which patients should be hospitalized?
• Which patients can be sent home safely and what follow-up is appropriate for them?
History
Obtaining an accurate history from the parent or caregiver is important when assessing fever without a focus; the history obtained should include the following information:
• Age in months
• Method of measurement of body temperature
• Fever history (onset of fever, degree, duration, progression
• Associated symptoms (running nose, nasal obstruction, cough, ear pulling and ear discharge, shortness of breath, rash, vomiting, diarrhea, ……..)
• How has the child looked (irritable, lethargic, playful….)
• Feeding & activity changes.
• Vaccination
Examination
• General look (conscious, unconscious, lethargic, irritable, cyanosis, dyspnic……)• Vital sings (pulse rate, respiratory rate, temperature)
• Measure pulse oximetry levels.
Pulse oximetry may be a more sensitive predictor of pulmonary infection than respiratory rate in patients of all ages, but especially in infants and young children.
Pulse oximetry is mandatory for any child with abnormal lung examination findings, respiratory symptoms, or abnormal respiratory rate.
• Rash
Examination
• Throat examination.• Ears examination for signs of infection (otitis media: congested tympanic membrane, bulging, perforation, loss of mobility using pneumatic otoscopy.
• Examination of chest and abdomen.
• Skin and soft tissue examination for evidence of skin or soft tissue infections.
Differential Diagnosis
Non-specific viral infectionViral upper respiratory tract infection
Otitis media
Bronchiolitis
Croup
Pneumonia
Sepsis
MeningitisGastroenteritis
UTI
Occult bacteremia
Others (measles , chickenpox, roseola infantum……..)
Most Frequent Diagnosis In Infants with Fever
Diagnostic testing
• Most infants and children with fever do not require laboratory investigations.• Specific groups of children requires laboratory investigation and includes those with:
• Temperature >38°C (rectal) and age <28 days.
• Temperature >38°C (rectal) ,age 28 to 90 days, and toxic-appearing.
• Temperature >39°C (rectal),age 91 days to 36 months, and toxic-appearing
Investigations includes
• CBC ,WBC (total and differential) and band neutrophil count• blood culture
• Urinalysis
• Urine culture
• Lumbar puncture and CSF culture
• Others (stool analysis, CXR……)
Blood cells count
White blood cell (WBC) counts and band neutrophil have been used to identify serious bacterial infection, including occult bacteremia .WBC count of 15,000/mm³ and more , and band neutrophil count of 1500/ mm³ and more suggest SBI.
Band neutrophils are an intermediary step prior to the complete maturation of segmented neutrophils. An increase in band neutrophils typically means that the bone marrow has been signaled to release more WBCs
and increase production of WBCs,
most often this is due to infection
or inflammation in the body.
Urine analysis and urine culture
Because UTI is a common cause of serious bacterial infection, urinalysis is a key factor in the evaluation of fever in infancy and early childhood.Urine sample should be obtained for all children younger than 24 months with unexplained fever.
The sample may be obtained by catheterization or suprapubic aspiration & in children with voluntary urine control, a clean catch method.
All samples should be sent for urine analysis and urine culture.
Lumber puncture
Lumber puncture is recommended for all febrile neonates, and for infants and young children with clinical signs of meningitis, such as neck rigidity, petechiae, or abnormal neurologic findings.Chest x-ray:
Chest radiography may be performed in all neonates with unexplained fever.
Chest radiography is also recommended for young children older than one month demonstrating respiratory symptoms, and for those with a fever of more than (39°C) and a WBC count of more than 20,000/mm³
Management
I. Management of fever in neonate (< 28 days)Those neonate assumed to have bacteraemia and, potential seeding to CSF, even if the source of infection discovered.
Work up should includes culture of blood, urine, CSF and stool (if GIT symptom present) and CXR if respiratory symptom present.
Child should be admitted for IV antibiotics until the result of cultures negative.
Antibiotic of choice: Ampicillin and cefotaxime or ampicillin and gentamicin are potential regimens that will provide empiric coverage for possible microorganisms until culture results are available.
II. Management of fever in infants 1-3 months
It is safest to assume that they are still unable to contain bacterial infection.
Patients at low risk of having SBI have the following criteria:
• Generally well appearing.
• No focal infection.
• WBC 5000-15,000/mm³
• Band form < 1500/ mm³.
• Normal urine analysis.
• Normal CSF.
• Stool microscopy < 5 WBC/hpf if diarrhea is present.
II. Management of fever in infants 1-3 months
If no source is found on exam, it is reasonable for patients meeting these low-risk criteria to be managed with intramuscular ceftriaxone in the ED/clinic—if follow-up can be arranged to receive a second dose in 24 hours.It should be emphasized that these infants are still vulnerable to dissemination of bacterial infections. Therefore, those with an obvious source, those who appear clinically ill, or those who do not meet the low-risk criteria should be cultured (blood, urine, CSF cultures) and admitted for IV antibiotics until cultures are negative.
III. Management of fever in children 3-36 months
It is generally accepted that well-appearing children at this age with fevers 39° C do not require further evaluation or antibiotics.Up to 5% of children with temperature 39° C who appear clinically well will have positive blood cultures (occult bacteremia), putting them at risk for serious infections.
One approach is to obtain screening WBC on those with fevers 39° C. If >15,000/mm3 or > 1,500 bands/mm3, then further evaluation of blood, urine, and CSF should be considered.